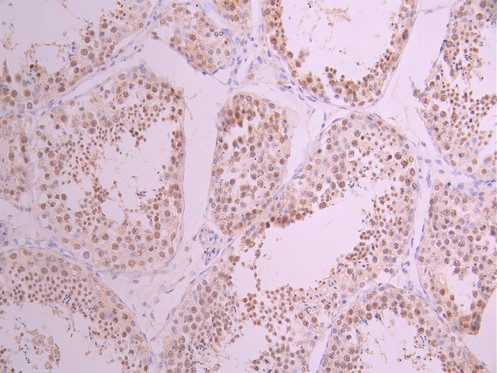

MCM2 Recombinant Monoclonal Antibody
-
中文名稱:MCM2 Recombinant Monoclonal Antibody
-
貨號:CSB-RA126181A0HU
-
規格:¥1320
-
圖片:
-
Western Blot
Positive WB detected in: Jurkat whole cell lysate(30μg), Raji whole cell lysate(30μg), HL-60 whole cell lysate(30μg), NIH/3T3 whole cell lysate(30μg)
All lanes:p-MCM2 (S27) antibody at 1:1000
Secondary
Goat polyclonal to rabbit IgG at 1/40000 dilution
Predicted band size: 102 kDa
Observed band size: 130 kDa
Exposure time:2min -
IHC image of CSB-RA126181A0HU diluted at 1:100 and staining in paraffin-embedded human cervical cancer performed on a Leica BondTM system. After dewaxing and hydration, antigen retrieval was mediated by high pressure in a citrate buffer (pH 6.0). Section was blocked with 10% normal goat serum 30min at RT. Then primary antibody (1% BSA) was incubated at 4°C overnight. The primary is detected by a Goat anti-rabbit polymer IgG labeled by HRP and visualized using 0.05% DAB.
-
IHC image of CSB-RA126181A0HU diluted at 1:100 and staining in paraffin-embedded human testis tissue performed on a Leica BondTM system. After dewaxing and hydration, antigen retrieval was mediated by high pressure in a citrate buffer (pH 6.0). Section was blocked with 10% normal goat serum 30min at RT. Then primary antibody (1% BSA) was incubated at 4°C overnight. The primary is detected by a Goat anti-rabbit polymer IgG labeled by HRP and visualized using 0.05% DAB.
-
Immunofluorescence staining of Hela cell with CSB-RA126181A0HU at 1:50, counter-stained with DAPI. The cells were fixed in 4% formaldehyde, permeabilized using 0.2% Triton X-100 and blocked in 10% normal Goat Serum. The cells were then incubated with the antibody overnight at 4°C. The secondary antibody was Alexa Fluor 488-congugated AffiniPure Goat Anti-Rabbit IgG(H+L).
-
Overlay Peak curve showing jurkat cells stained with CSB-RA126181A0HU (red line) at 1:100. The cells were fixed in 4% formaldehyde and permeated by 0.2% TritonX-100 for 10min. Then 10% normal goat serum to block non-specific protein-protein interactions followed by the antibody (1ug/1*106cells) for 45min at 4℃. The secondary antibody used was FITC-conjugated goat anti-rabbit IgG (H+L) at 1/200 dilution for 35min at 4℃.Control antibody (green line) was Rabbit IgG (1ug/1*106cells) used under the same conditions. Acquisition of >10,000 events was performed.
-
-
其他:
產品詳情
-
Uniprot No.:
-
基因名:
-
別名:DNA replication licensing factor MCM2 (EC 3.6.4.12) (Minichromosome maintenance protein 2 homolog) (Nuclear protein BM28), MCM2, BM28 CCNL1 CDCL1 KIAA0030
-
反應種屬:Human, Mouse
-
免疫原:A synthesized peptide from human MCM2 protein
-
免疫原種屬:Homo sapiens (Human)
-
標記方式:Non-conjugated
-
克隆類型:Monoclonal
-
抗體亞型:Rabbit IgG
-
純化方式:Affinity-chromatography
-
克隆號:7D10
-
濃度:It differs from different batches. Please contact us to confirm it.
-
保存緩沖液:Preservative: 0.03% Proclin 300
Constituents: 50% Glycerol, 0.01M PBS, PH 7.4 -
產品提供形式:Liquid
-
應用范圍:ELISA, WB, IHC, IF, FC
-
推薦稀釋比:
Application Recommended Dilution WB 1:500-1:2000 IHC 1:50-1:200 IF 1:50-1:200 FC 1:50-1:200 -
Protocols:
-
儲存條件:Upon receipt, store at -20°C or -80°C. Avoid repeated freeze.
-
貨期:Basically, we can dispatch the products out in 1-3 working days after receiving your orders. Delivery time maybe differs from different purchasing way or location, please kindly consult your local distributors for specific delivery time.
-
用途:For Research Use Only. Not for use in diagnostic or therapeutic procedures.
相關產品
靶點詳情
-
功能:Acts as component of the MCM2-7 complex (MCM complex) which is the putative replicative helicase essential for 'once per cell cycle' DNA replication initiation and elongation in eukaryotic cells. The active ATPase sites in the MCM2-7 ring are formed through the interaction surfaces of two neighboring subunits such that a critical structure of a conserved arginine finger motif is provided in trans relative to the ATP-binding site of the Walker A box of the adjacent subunit. The six ATPase active sites, however, are likely to contribute differentially to the complex helicase activity. Required for the entry in S phase and for cell division. Plays a role in terminally differentiated hair cells development of the cochlea and induces cells apoptosis.
-
基因功能參考文獻:
- The findings suggest that Mcm-2 may be a sensitive proliferation marker in oral potentially malignant and malignant lesions which may be useful for differentiating between Verrucous Hyperplasia (VH) with/ without dysplasia, Verrucous Carcinoma (VC) and Oral Squamous Cell Carcinoma (OSCC). PMID: 29661732
- High MCM2 expression is associated with HIV-1 infection. PMID: 29084722
- The results showed that MUS81 modulates MCM2 levels as well as homologous recombination (HR) activity. Moreover, downregulation of MUS81 increased the sensitivity of epithelial ovarian cancer (EOC)cells to olaparib by inducing S phase arrest and promoting apoptosis through activation of MCM2. MUS81 may be a potential novel therapeutic target for EOC. PMID: 29393493
- MCM2 played important roles in regulating cell cycle- and DNA replication-related pathways. E2F could upregulate the expression levels of MCM2 by deregulating the methylations of their promoters to promote the relapse of Acute Lymphoblastic Leukemia . PMID: 29768346
- ProEx C is an immunohistochemical cocktail containing antibodies direct against topoisomerase IIalpha (TOP2A) and minichromosome maintenance 2 (MCM2) proteins. This brief review covers the effective utility of ProEx C as adjunct tool in assessing the urothelial lesions in urine cytology, also providing prognostic and therapeutic information to help in clinical decisions. PMID: 28638271
- the decreased growth of osteosarcoma cells by MCM2 or MCM3 knockdown was reversed by DHX9 overexpression, indicating that MCM2 and MCM3 activity was DHX9-dependent. PMID: 28460433
- Results show that MCM2 is significantly upregulated in urothelial carcinoma. PMID: 27780919
- Sld5 a component of GINS complex interacts with SIK1 and recruits it to the sites of DNA replication at the onset of S phase. PMID: 27592030
- MCM2 expression in serrated colonic polyps demonstrates aberrant cellular proliferation and changes in the colonic microenvironment may promote adenoma morphogenesis and predisposition to malignancy. PMID: 28302537
- these findings suggest that lnc-FTX may act as a tumor suppressor in hepatocellular carcinoma (HCC) through physically binding miR-374a and MCM2. It may also be one of the reasons for HCC gender disparity and may potentially contribute to HCC treatment PMID: 27065331
- Data suggest that interaction of Mcm10 with Mcm2-7 multimer requires Mcm10 domain that contains amino acids 530-655, which overlaps with domain required for stable retention of Mcm10 on chromatin; Mcm10 conserved domain (amino acids 200-482) is essential for DNA replication; both conserved domain and Mcm2-7-binding domain are required for full activity of Mcm10. PMID: 28646110
- MCM2-MCM6 complex is required for CHK2 chromatin loading and its phosphorylation to DNA damage response in squamous cell carcinoma cells. PMID: 27964702
- BD ProExtrade mark C assay containing MCM2 and TOP2A antibodies showed strong specific nuclear staining that correlated with increased cervical dysplasia and lesion severity. PMID: 28093271
- these data suggest that positive MCM2 and negative TIP30 expression are closely correlated with the clinical, pathological and biological parameters, in addition to poor prognosis in patients with gallbladder cancer. PMID: 27748889
- knockdown of MCM2 or MCM6 could significantly inhibit foci forming of MDC1 in TE-1 nuclei in response to bleomycin-induced DNA damage (p < 0.001). This study indicates the direct interaction between MDC1 and MCMs in TE-1 nuclei. PMID: 27908247
- PTEN regulates DNA replication through MCM2 and loss of PTEN function leads to replication defects and genomic instability. PMID: 26549452
- MCM2 expression is higher in ovarian and endometrial high-grade serous carcinomas (HGSC) than in ovarian or endometrial endometrioid carcinoma. Knockdown in ovarian HGSC cell line decreased cell proliferation. PMID: 26889980
- quaternary complex of histone H3-H4 heterodimer with chaperone ASF1 and the replicative helicase subunit MCM2 PMID: 26186914
- MCM2 is a novel gene responsible for nonsyndromic hearing loss of autosomal dominant inheritance in a Chinese family. PMID: 26196677
- The findings indicated that Mcm-2 could be a useful marker for early detection of oral squamous cell carcinoma PMID: 26712671
- MCM2 may be a novel therapeutic target of lovastatin treatment in NSCLCs. PMID: 25738322
- minichromosome maintenance protein-2 may serve as a useful marker in the screening of cervical carcinoma and precancerous lesions and improve the diagnosis of atypical squamous cell of undetermined significance PMID: 25755789
- Data indicate that minichromosome maintenance protein 2 (MCM2) binding is not required for incorporation of histone H3.1-H4 into chromatin but is important for stability of H3.1-H4. PMID: 26167883
- The data suggest that MCM2 is not a good biomarker when comparing the different clinical stages of cervical cancer. PMID: 24706378
- Thermodynamic analysis of the quaternary complex together with structural modeling support that ASF1 and MCM2 could form a chaperoning module for histones H3 and H4 protecting them from promiscuous interactions. PMID: 25618846
- Data suggest that minichromosome maintenance complex component 2 (MCM2) is a likely target gene of microRNA-31. PMID: 24970811
- Results show that in Glioma patients, MCM 2, MCM3 and MCM7 mRNA are up-regulated and correlated with poor outcome. PMID: 25046975
- Of the total, the deregulation of several genes (CDK1, CDK2, CDK4, MCM2, MCM3, MCM4, EIF3a and RPN2) were potentially associated with disease development and progression. PMID: 24386425
- MCM2/TOP2A immunohistochemistry can help to support a diagnosis of true dysplasia for patients without a history of head and neck cancer. PMID: 24630889
- ORC/Cdc6/MCM2-7 complex is a new regulatory mechanism for the helicase. PMID: 23803736
- Mcm2-7 loads onto origins during initiation as a double hexamer, yet does not act as a double-stranded DNA pump during elongation. PMID: 22918583
- MCM-2 is a therapeutic target of Trichostatin A in colon cancer cells. PMID: 23770000
- Mcm2 expression and DNA ploidy analysis could be used to predict areas of malignant transformation in oral proliferative verrucous leukoplakia. PMID: 23347057
- MCM2 is a sensitive, specific and efficient biomarker of gastric cardiac cancer having potential use in the clinic. PMID: 23329420
- Immunohistochemical expression of minichromosome maintenance complex protein 2 predicts biochemical recurrence in prostate cancer. PMID: 22554381
- The results of this study indicated that the higher MCM-2 expressions in RC than the KCOT might be related to the inflammation and this protein might be more sensitive to inflammation. PMID: 22778705
- ProEx C showed the best specificity; p16 displayed the highest sensitivity and area under receiver operating characteristic curve for squamous intraepithelial lesions diagnosis. PMID: 22590819
- Data show that using a 200-nt primed circular DNA substrate, the combined action of DNA polymerase epsilon and the Cdc45/Mcm2-7/GINS (CMG complex) leads to the formation of products >10 kb in length. PMID: 22474384
- The up-regulated expression of MCM2 is associated with frequent apoptosis in myelodysplastic syndromes (MDS) and may have an important role in the pathogenesis of MDS. PMID: 22115939
- ProExC expression is not associated with HPV in squamous cell carcinoma in situ of the skin PMID: 20184667
- Our data suggest that MCM2 could serve as a novel prognostic biomarker in gastric carcinoma. PMID: 21947329
- Salivary gland carcinomas express maspin and MCM2 with variable levels and cellular localization PMID: 21943228
- MCM2 is a promising prognostic factor in wilm's tumor treated according to the SIOP scheme PMID: 21866463
- overexpression of MCM2 or loss of expression of Tat-interacting protein 30 is closely related to carcinogenesis, progression, biological behavior, and prognosis of gallbladder adenocarcinoma. PMID: 21543106
- Lymph node sections from 138 HL patients were immunohistochemically stained for cyclin D3 (CCND3), MCM2 and MCM7 aiming to investigate clinical outcome. PMID: 21965782
- These results suggest that HERC2 regulates DNA replication progression and origin firing by facilitating MCM2 phosphorylation. PMID: 21775519
- evaluated the intensity of metallothionein expression in various histological types of non-small cell lung cancer and correlated expression intensity with pathological parameters and Ki-67 and minichromosome maintaince protein 2 proliferation markers PMID: 21868526
- MT-I/II may play a key role in IDC proliferation, but is not a useful prognostic factor of this disease PMID: 21868554
- lack of MCM2, proteins expression which may explain commonly known low mitotic activity of desmoid tumour cells PMID: 21478101
- Study shows that despite the predominantly different localization of MCM 2 and replication signals, there is still a small but significant fraction of MCM 2 proteins that co-localize with DNA replication foci during most of S phase. PMID: 21457648
顯示更多
收起更多
-
相關疾病:Deafness, autosomal dominant, 70 (DFNA70)
-
亞細胞定位:Nucleus. Chromosome.
-
蛋白家族:MCM family
-
數據庫鏈接:
Most popular with customers
-
-
YWHAB Recombinant Monoclonal Antibody
Applications: ELISA, WB, IHC, IF, FC
Species Reactivity: Human, Mouse, Rat
-
Phospho-YAP1 (S127) Recombinant Monoclonal Antibody
Applications: ELISA, WB, IHC
Species Reactivity: Human
-
-
-
-
-